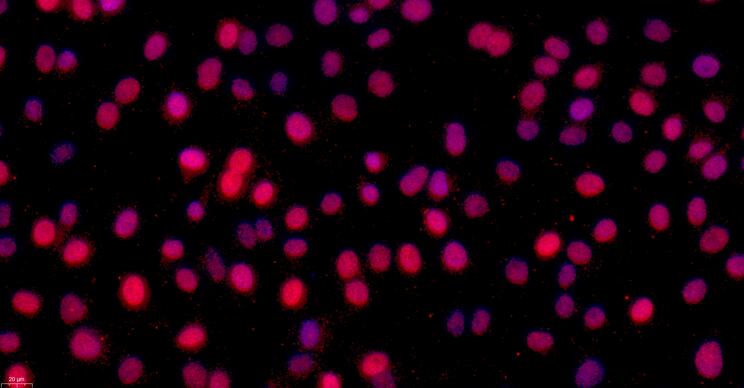
32076

Назначение
первичные клетки получены из организма кролик и представляют ценный материал для биомедицинских исследований. Клетки происходят из ткани и характеризуются типом роста: адгезивный.
Преимущества
- Высокая жизнеспособность и пролиферативная активность
- Сохранение естественных морфофункциональных характеристик
- Стабильность в культуре
- Соответствие международным стандартам качества
Применение в исследованиях
Клетки могут использоваться для изучения клеточных механизмов, скрининга лекарственных препаратов, токсикологических исследований и решения фундаментальных задач биомедицины.
Условия культивирования
. Рекомендуется строгое соблюдение протоколов культивирования для поддержания оптимального состояния клеток.